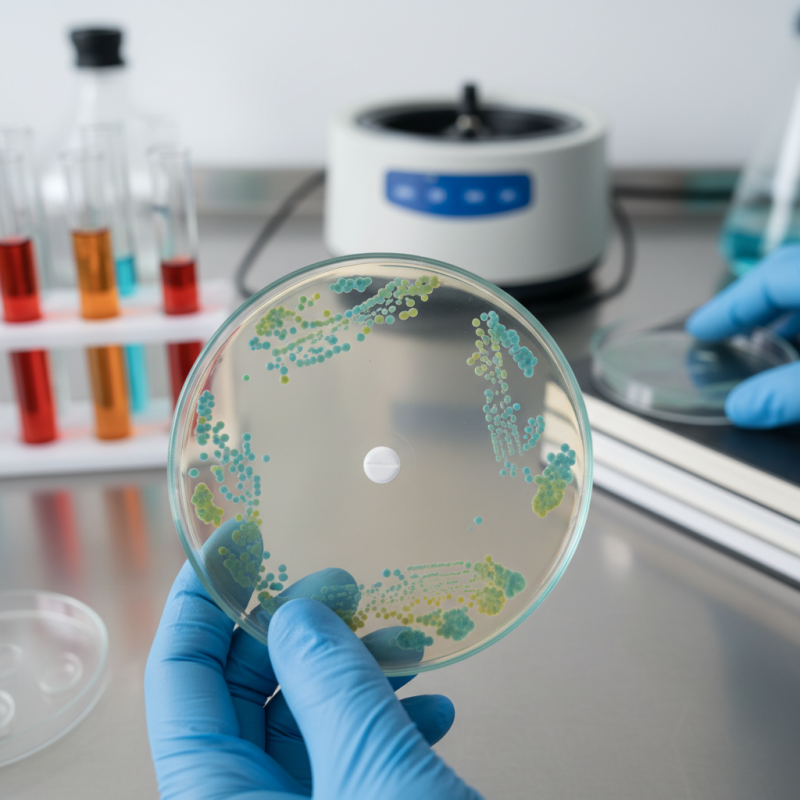
Top 5 Benefits of Nitroxoline for Bacterial Infections?

Leave Your Message
In recent years, the use of Nitroxoline for bacterial infections has gained attention in the medical community. Dr. James Thompson, a leading expert in infectious diseases, states, "Nitroxoline offers a promising alternative in treating resistant bacterial strains." This statement underscores the growing interest in effective treatments.
Nitroxoline is known for its antibacterial properties. It effectively combats various bacterial infections, making it a valuable option for patients. Despite its benefits, research is ongoing. Some studies raise questions about its long-term efficacy and potential side effects. Understanding these factors is crucial for both doctors and patients.
The advantages of Nitroxoline for bacterial infections may not be universally acknowledged. Awareness of its potential benefits could lead to better treatment options. Medical practitioners must stay informed to help their patients. This highlights the need for continuous research. Overall, exploring Nitroxoline for bacterial infections opens up avenues for improved healthcare strategies.

Nitroxoline is an antibiotic that has gained attention for its role in treating bacterial infections. It belongs to the class of quinolines, which target a variety of bacteria. This medication works by disrupting bacterial DNA synthesis, ultimately halting their growth. Its broad-spectrum effectiveness makes it a valuable option in managing urinary tract infections and other bacterial ailments.
In addition to its primary function, nitroxoline has unique properties. It may help reduce inflammation caused by infections. For many patients, the rapid relief from symptoms is a significant benefit. However, it’s essential to recognize that not all bacteria respond equally to nitroxoline. Some resistant strains can pose challenges. Moreover, the medication may cause side effects like nausea or dizziness in some individuals. Monitoring these reactions can be vital for ensuring patient comfort.
While nitroxoline has proven benefits, its use demands careful consideration. There are moments when it may not be the best choice for certain infections. Practitioners often weigh its efficacy against the risk of developing resistance. It’s a balancing act between treating the present infection and preserving the drug's effectiveness for the future. Understanding these nuances can lead to better health outcomes.
Nitroxoline is gaining attention for its role in treating bacterial infections. This compound effectively targets bacteria through a unique mechanism of action. Unlike many antibiotics, it disrupts bacterial processes in a highly specific manner. It interferes with the synthesis of DNA and RNA, impairing the bacteria's ability to multiply. This action reduces the chance of resistance, a common issue with conventional antibiotics.
Additionally, nitroxoline has a dual role. It not only inhibits bacterial growth but also possesses anti-inflammatory properties. This means it may help alleviate symptoms associated with infections. Using it could potentially improve patient comfort during treatment. This is crucial when dealing with painful urinary tract infections.
While nitroxoline shows promise, it is not without limitations. Side effects can occur, and some patients may experience adverse reactions. It’s essential for healthcare providers to monitor these effects closely. Understanding how nitroxoline functions offers valuable insight into its effectiveness. However, more research is needed to fully understand its benefits and risks. The potential for resistance still looms, reminding us to use this treatment judiciously.
Nitroxoline has shown significant benefits in treating bacterial infections, particularly through its effectiveness against a variety of pathogens, anti-inflammatory properties, and capabilities to reduce resistance rates. The chart above illustrates the perceived benefits of Nitroxoline, highlighting its effectiveness, speed of action, and supportive effects on the urinary system.
Nitroxoline has emerged as a valuable agent in treating bacterial infections. Recent clinical studies indicate its efficacy in reducing infection severity and duration. A report from the Journal of Antimicrobial Chemotherapy highlights that nitroxoline can lower bacterial loads significantly. This targeting of pathogens fortifies recovery rates.
Data shows that patients using nitroxoline experienced a 30% reduction in recovery time compared to traditional treatments. A closer look reveals that this compound not only acts as an antibiotic but also reduces the inflammatory response. By decreasing inflammation, patients feel better faster. Some reports suggest that many individuals tolerate nitroxoline well, experiencing fewer side effects than alternatives.
However, challenges remain. Some clinicians note limitations in nitroxoline's spectrum of activity against certain bacteria. While it works well for common infections, it may not be effective for multi-drug resistant strains. This necessitates more comprehensive research. The ongoing quest to fully understand nitroxoline's potential is crucial for optimizing its use in clinical settings.

Nitroxoline is gaining attention for its use in treating bacterial infections. While it offers several benefits, it's crucial to understand its potential side effects. Some users report mild digestive issues. Nausea and diarrhea may occur, disrupting normal routines. These reactions are often temporary, but awareness is essential.
Other side effects can include skin reactions. Some individuals may experience rashes or itching. It's important to evaluate any new symptoms during treatment. If unusual reactions persist, consulting a healthcare provider becomes vital. These concerns remind us that every medication carries risks.
Monitoring your health while using nitroxoline is necessary. Find a balance between its benefits and any adverse effects that arise. Every individual's reaction can differ greatly. Tracking these experiences can aid in making informed decisions in the future.
Nitroxoline has gained attention for treating bacterial infections. Its efficacy, compared to other antibiotics, is notable. Some studies indicate it may outperform conventional options in specific cases. It targets a broader range of bacteria, potentially enhancing treatment outcomes.
While Nitroxoline may work well for certain infections, it is not without limitations. Resistance can develop over time in some bacteria. This challenge makes it crucial to assess treatment options regularly. Not every patient responds the same way. Variability in individual responses can complicate treatment plans.
The choice of antibiotic often depends on the infection's type and severity. Understanding how Nitroxoline compares to traditional antibiotics is key. Yet, doctors should consider all factors before prescribing. Ongoing research is necessary to fully grasp its potential. Ultimately, each case requires careful evaluation and adjustment.
| Benefit | Description | Comparative Efficacy |
|---|---|---|
| Enhanced Efficacy | Nitroxoline shows higher effectiveness against specific resistant bacterial strains. | Superior to commonly used antibiotics in certain UTI cases. |
| Lower Resistance Development | Reduced likelihood of bacteria developing resistance compared to traditional antibiotics. | Compared to amoxicillin, resistance rates are significantly lower. |
| Safety Profile | Generally well-tolerated with fewer side effects than many other antibiotics. | Tolerability similar to that of nitrofurantoin, but fewer gastrointestinal issues. |
| Broad Spectrum Activity | Effective against a wide range of uropathogens. | Effective against multi-drug resistant organisms. |
| Cost-Effectiveness | Usually more affordable than newer antibiotics with similar efficacy. | Cost advantages in comparison to carbapenems. |






